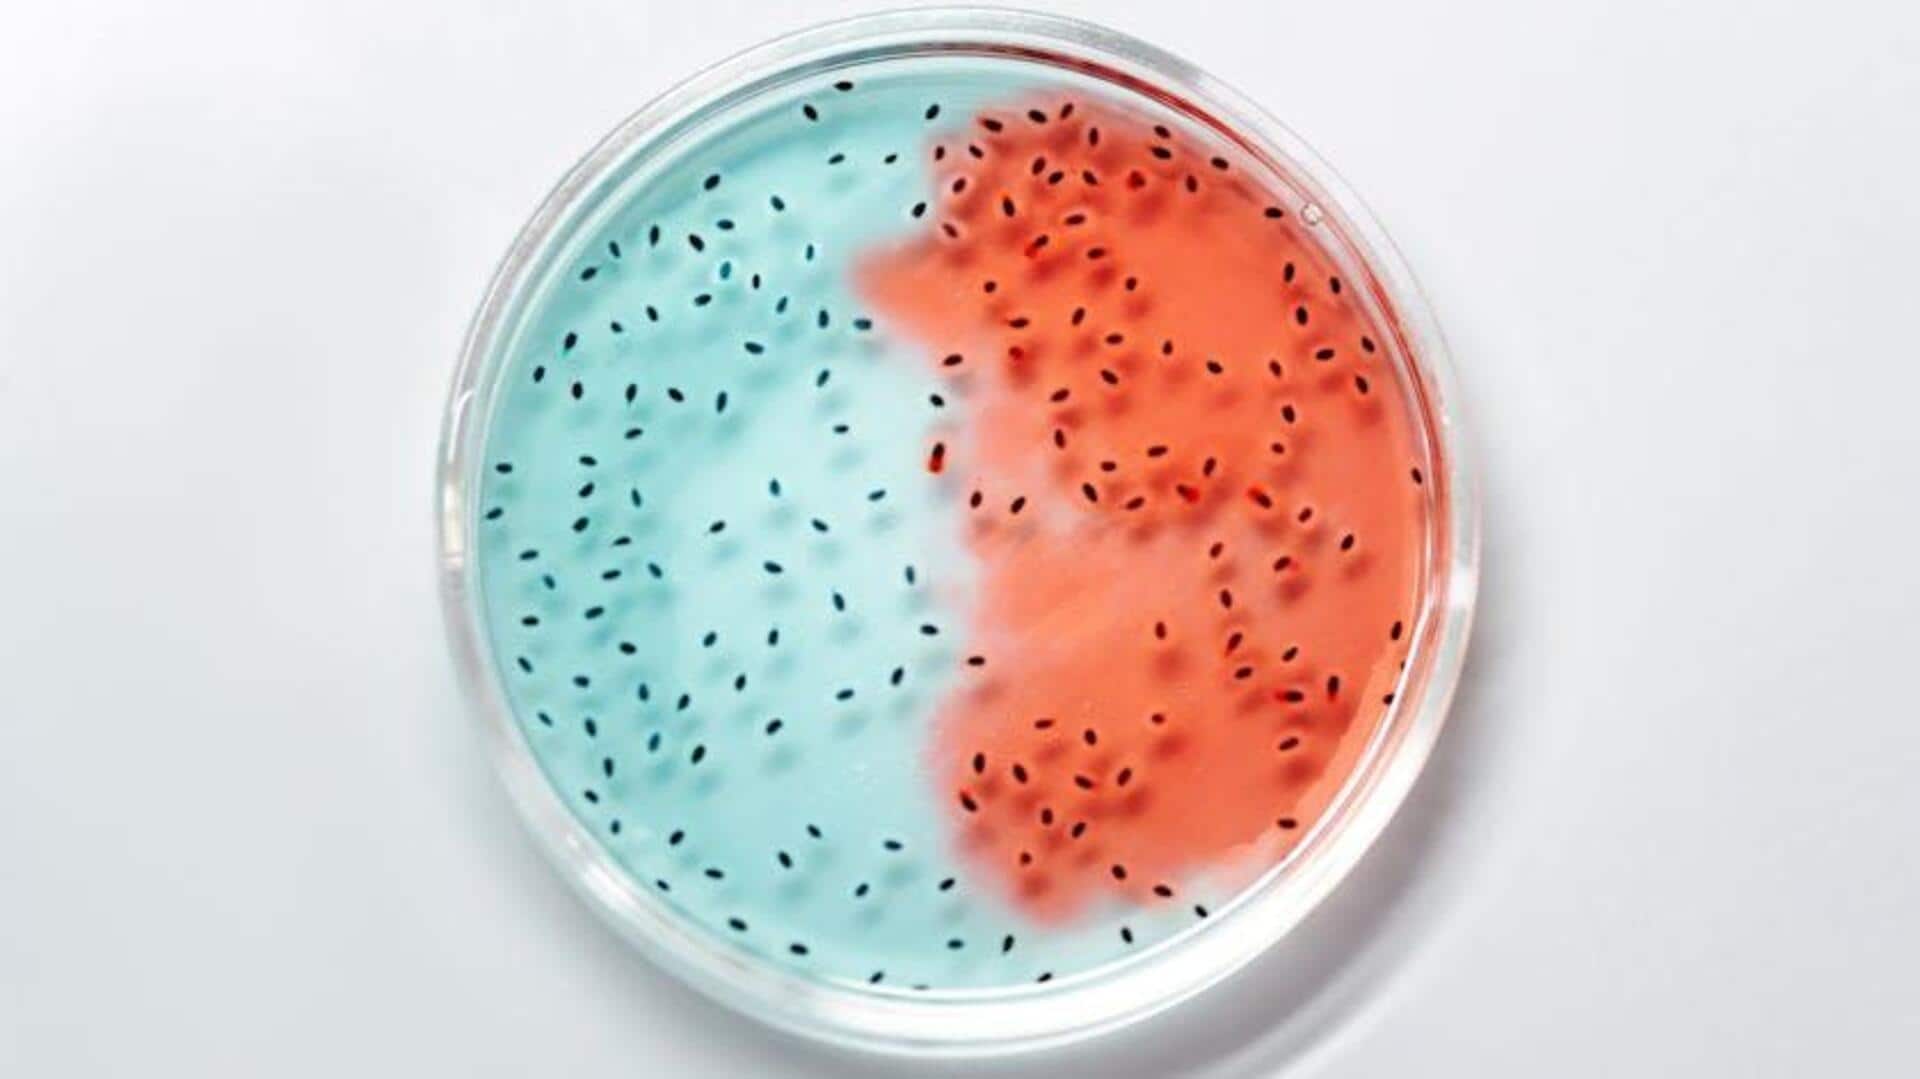
Mikroba Tak Terlihat yang Mengubah Pembersihan Tumpahan Minyak Global

Mikroba Tak Terlihat yang Mengubah Pembersihan Tumpahan Minyak Global
Apa ceritanya
Tumpahan minyak adalah masalah lingkungan serius yang mempengaruhi ekosistem laut dan pesisir. Namun, kemajuan dalam bioteknologi telah memperkenalkan solusi inovatif: mikroba tak terlihat yang dapat membantu membersihkan tumpahan minyak. Mikroba ini memiliki kemampuan alami untuk memecah minyak menjadi senyawa yang lebih aman, menawarkan pendekatan ramah lingkungan untuk mengatasi masalah ini.
Konsep Utama
Peran Mikroba dalam Pembersihan Tumpahan Minyak
Mikroba seperti bakteri dan jamur memiliki enzim khusus yang dapat menguraikan hidrokarbon dalam minyak. Proses ini dikenal sebagai biodegradasi. Dengan memanfaatkan mikroba ini, kita dapat mempercepat proses pembersihan secara alami tanpa merusak lingkungan lebih lanjut. Pendekatan ini tidak hanya efektif tetapi juga berkelanjutan, menjadikannya pilihan menarik bagi upaya pembersihan global.
Manfaat Utama
Keunggulan Penggunaan Mikroba
Penggunaan mikroba untuk membersihkan tumpahan minyak menawarkan beberapa keunggulan signifikan. Pertama, metode ini lebih ramah lingkungan dibandingkan dengan teknik kimia tradisional yang sering kali meninggalkan residu berbahaya. Kedua, mikroba dapat bekerja secara mandiri di bawah air atau tanah, menjangkau area sulit dijangkau oleh metode konvensional. Terakhir, pendekatan ini lebih ekonomis dalam jangka panjang karena mengurangi kebutuhan akan bahan kimia mahal.
Tantangan dan Solusi
Tantangan dan Solusi Potensial
Meskipun menjanjikan, penggunaan mikroba dalam pembersihan tumpahan minyak menghadapi beberapa tantangan seperti kondisi lingkungan yang tidak mendukung atau keberadaan nutrisi terbatas bagi mikroba tersebut. Untuk mengatasi hal ini, penelitian terus dilakukan untuk meningkatkan efektivitas mikroba melalui rekayasa genetika atau penambahan nutrisi buatan agar proses biodegradasinya lebih optimal dan cepat.
Masa Depan
Masa Depan Pembersihan Tumpahan Minyak
Dengan terus berkembangnya teknologi bioteknologi dan pemahaman kita tentang ekosistem laut, penggunaan mikroba dalam pembersihan tumpahan minyak diperkirakan akan semakin meningkat di masa depan. Inovasi-inovasi baru akan terus muncul seiring dengan kebutuhan global akan solusi pembersihan yang lebih berkelanjutan dan efektif terhadap dampak lingkungan dari tumpahan minyak di berbagai belahan dunia.